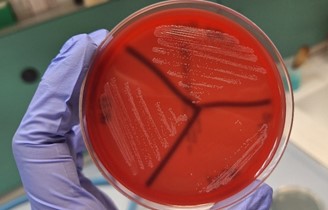

Author: Annarita
-
ECM – Terza Giornata dei Centri e dei Laboratori di Referenza Nazionali degli IZS nell’ottica One Health
Sono aperte le iscrizioni al corso ECM dal titolo “Terza Giornata dei Centri e dei Laboratori di Referenza Nazionali degli Istituti Zooprofilattici Sperimentali nell’ottica One ... -
Caratterizzazione di Photobacterium damselae subsp. piscicida isolato da un episodio di mortalità di massa nel cefalo comune (Mugil cephalus) nel mar Ionio
Il laboratorio di biologia molecolare della sezione di Putignano dell’Istituto Zooprofilattico Sperimentale della Puglia e della Basilicata ha recentemente sequenziato e depositato nel database ... -
Diversità genetica dei virus influenzali suini nel Nord Est e identificazione di due nuovi genotipi
Ricercatori dell’IZSVe hanno identificato due genotipi di virus influenzali finora sconosciuti in Italia, denominati Novel 1 e Novel 2, in popolazioni di suini. La scoperta è ... -
Parassita della leishmaniosi è vettore per inibire Alzheimer
Il parassita della leishmaniosi diventa un vettore per inibire l’Alzheimer. Lo rivela uno studio dell’Università Statale di Milano, pubblicato sul Journal of Neuroinflammation, che ... -
A Bologna gatti malati di influenza aviaria. E l’Università avvia uno studio
Nemmeno i gatti sfuggono all’influenza aviaria. I nostri animali domestici possono essere contagiati esattamente come gli essere umani e in provincia di Bologna per un ... -
Bluetongue in Europa e in Italia: vecchie conoscenze e nuovi scenari
La febbre catarrale degli ovini o Bluetongue (BT) è una malattia infettiva non contagiosa che colpisce alcune famiglie dell’ordine degli Artiodattili ed è trasmessa ... -
Rapporto Unep: il mondo sulla rotta dei 2,5 gradi di riscaldamento globale
La prossima settimana, a Belém in Brasile, si aprirà la trentesima Conferenza mondiale sul clima delle Nazioni Unite, la Cop30. Delegazioni governative, organizzazioni della ... -
Sicurezza alimentare, benessere e sostenibilità: al via l’accordo IZSLT–API per l’acquacoltura del futuro
Rafforzare la sicurezza sanitaria, promuovere il benessere animale e sostenere la sostenibilità delle produzioni ittiche: sono questi gli obiettivi principali dell’accordo triennale siglato tra ... -
One Health, l’Ingrediente mancante: la SIMeVeP al centro del dibattito a Welfair la Fiera del fare Sanità.
One Health, L’Ingrediente Mancante: La SIMeVeP al Centro del Dibattito a Welfair la Fiera del fare Sanità. Maurizio Ferri 4-7 Novembre 2025, Fiera di ... -
Dieci anni dall’Accordo di Parigi, si può fare di più
Con l’Accordo di Parigi (dicembre 2015), i Paesi si sono impegnati a elaborare i propri piani di riduzione delle emissioni di gas serra, noti ...